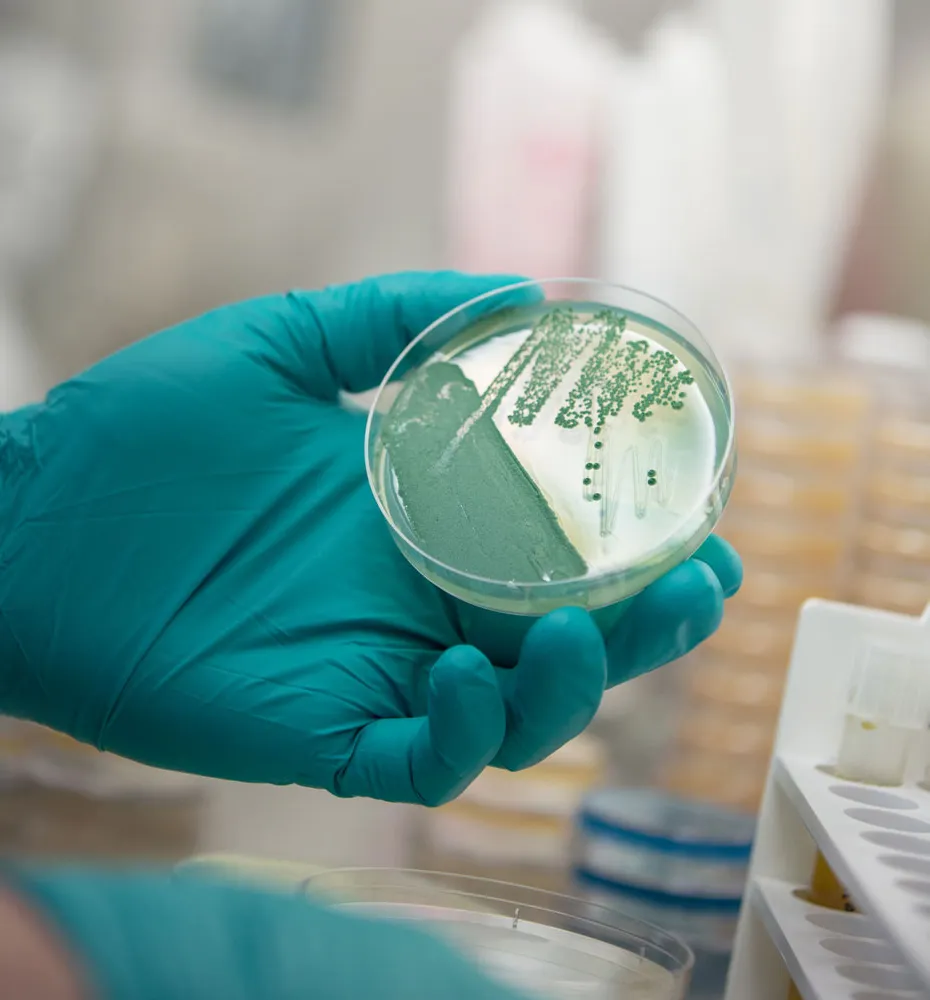
Vaccination' title='Qu’est-ce qui donne un goût aigre à une bière aigre ?

Craftbeer.com
Craftbeer.comC’est à l’arrière d’un vieux sous-sol de stockage miteux. Le sol est fait de terre et il y a un léger filet d’eau rythmé qui coule quelque part à proximité. L’odeur fade du moût emplit l’air. Au fond d’une cave de fermentation se trouve une petite bouteille solitaire qui semble si poussiéreuse qu’elle est sur le point d’être récupérée par Mère Nature elle-même.
Pourtant, dans cette bouteille, depuis quelque temps, une guerre fait rage. C’est une guerre microscopique avec les bactéries et les levures comme pions et un certain profil de saveur délicate comme objectif.
cv brassage
( LIRE: Qu’est-ce que le label de brasseur artisanal indépendant ? )
Il fut un temps où les produits de ces batailles moléculaires étaient presque aussi infimes et marginalisés que les batailles elles-mêmes. Mais récemment, tout a changé. Les bières acidulées, même brouillon d'histoire qu'elles sont, ont le vent en poupe ! Ce ne sont peut-être plus les bières blondes croustillantes et droites que nous connaissions. En fait, certains d’entre eux s’approchent même de l’antithèse de cela. Ils sont profondément complexes et mystérieux.
Avec de plus en plus de bouteilles de cet élixir ésotérique sorties des profondeurs de diverses caves de fermentation du monde entier, les bières acidulées explosent sur la scène artisanale américaine. Mais beaucoup en savent très peu sur eux. Comment ces bières tentent-elles le novice hésitant ou incitent-elles le consommateur amateur d’IPA à s’écarter du délicieux terrier du lapin ? C'est simple. Ils attendent que vous parliez à quelqu'un qui s'y connaît comme un brasseur ou un barman.
Qu'est-ce qui rend une bière aigre ?
Il est d’abord important de comprendre que les bières acidulées sont ambiguës. Nous avons écrit précédemment sur la difficulté particulière de catégoriser les bières acidulées. Ils sont tout aussi difficiles à réaliser.
Ils comprennent de nombreux styles traversant plusieurs régions du globe et varient en alcool et en couleur. Leur seule caractéristique fédératrice : une saveur décalée. Une variation subjective du goût qui existe sur un spectre allant d'une sorte de funk étrange à une saveur purement acide de vinaigre. Cependant, c'est là qu'il faut se concentrer sur la notion de ce qui rend une bière aigre, car c'est dans le processus de production que l'on rend la bière aigre.
Après cette introduction complexe et nébuleuse, je souhaite injecter un peu de simplicité. Pour fabriquer une bière (n'importe quelle bière), les brasseurs aigre-doux l'inoculent. Qu'est-ce que cela signifie? Ils fermentent simplement la bière en introduisant un (ou une combinaison) d'agents de fermentation : un genre de levure appelée bactérie productrice d'acide Brettanomyces et/ou tout type de levure conventionnelle et non conventionnelle.
Après cette introduction complexe et nébuleuse, je souhaite injecter un peu de simplicité. Pour fabriquer une bière (n'importe quelle bière), les brasseurs aigre-doux l'inoculent. Qu'est-ce que cela signifie? Ils fermentent simplement la bière en introduisant un (ou une combinaison) d'agents de fermentation : un genre de levure appelée bactérie productrice d'acide Brettanomyces et/ou tout type de levure conventionnelle et non conventionnelle.
( APPRENDRE: Cours en ligne Bière 101 )
Lorsque vous faites de la bière, vous faites fermenter le moût (bière brassée mais non fermentée) avec l'une des nombreuses espèces de levure Saccharomyces. Ces levures consomment les sucres disponibles dans le moût pour produire de l'alcool et du dioxyde de carbone ainsi qu'une gamme de caractéristiques aromatiques.
Les levures de bière conventionnelles comme celles de votre stout ou IPA préférée ont été isolées pour produire une fermentation contrôlée afin que la bière ait un goût constant. Mais ce n’est pas le cas lorsqu’il s’agit de bières dites acides qui sont principalement ou partiellement fermentées avec des bactéries productrices d’acide et des levures sauvages telles que les Brettanomyces.
Brettanomyces prête des saveurs complexes
Souvent appelé genre de levure sauvage Brettanomyces (ou Brett en abrégé) est souvent incorporé en combinaison avec une espèce traditionnelle de Saccharomyces pendant la fermentation de la bière intentionnellement (bien que Brett soit assez prolifique et capable de trouver une source de nourriture simplement en attrapant une brise ou en faisant un tour sur un équipement mal nettoyé. Cela peut faire des ravages dans une brasserie.)
Bien qu'il soit souvent qualifié à tort d'organisme acidifiant, le Brettanomyces est un genre producteur d'acide qui, en présence d'oxygène, peut métaboliser l'alcool en une acidité vinaigrée connue sous le nom d'acide acétique.
(APPRENDRE: Glossaire de la bière de CraftBeer.com )
Parallèlement à cette acidité, Brett prête une gamme complexe de composants aromatiques. Ces saveurs vont du terreux et funky aux fruits tropicaux. Ils peuvent se développer tout au long du processus de fermentation, de la fermentation primaire au vieillissement secondaire en barrique en passant par le conditionnement tertiaire en bouteille.
Lorsqu'ils utilisent de la levure sauvage comme Brett, certains brasseurs laissent le moût dans des cuves ouvertes. connus sous le nom de coolships pour leur permettre de capter les levures sauvages et les bactéries de l’environnement pour lancer la fermentation. Les brasseurs déplacent ensuite le moût dans des fûts de chêne où il évoluera lentement au fil du temps, produisant certaines des bières les plus complexes qui existent.
Comprendre Lactobacillus et Pediococcus
Les bactéries productrices d'aigre jouent un rôle en tandem dans la création de bière aigre avec Brett. Les principales souches bactériennes responsables de l’acidité des bières acides sont les Lactobacillus et les Pediococcus. Ces organismes peuvent être introduits dans le processus de brassage de diverses manières. Comme la levure, les bactéries consomment la nourriture disponible et produisent de l'acide comme sous-produit. Les deux produisent de l’acide lactique au caractère acidulé et citronné que l’on retrouve dans le yaourt ou la Berliner Weisse.
Un autre acide courant dans les bières acides est l’acide acétique. L'acide acétique est un autre sous-produit dérivé de la levure et est l'acide responsable du caractère du vinaigre. L'acide acétique est également produit par l'acétobactérie, une bactérie d'altération qui consomme de l'alcool oxydé.

Le risque vient avec le brassage de bières aigres
C’est une bonne occasion de donner un aperçu d’une autre question bonus : pourquoi les brasseries ne font-elles pas plus de sours ?
C’est une bonne question.
Eh bien, si votre intention est d’inoculer la bière avec ces microbes sauvages et difficiles à manier, sachez qu’ils peuvent être difficiles à tuer et qu’ils sont tenaces si vous ne les tuez pas tous. Fondamentalement, peu de brasseries le font car il existe un risque inhérent d’infecter plus que la bière prévue et de voir une infection se propager comme une septicémie dans toute la brasserie.
( CUISINEZ AVEC DE LA BIÈRE : Trouvez des centaines de recettes )
Existe-t-il différents types de sours ?
Bien sûr, il y a une manière ou une organisation à cela : nous ne sommes pas des animaux. Cela dit, ce n’est pas extrêmement simple. En fait, il évolue constamment.
Grâce aux brasseries innovantes du monde entier et aux scientifiques fous qui s'efforcent sans cesse de repousser les limites, le nombre de catégories spécifiques de bière aigre ne cesse de croître et de changer. Le Programme de certification des juges de bière (BJCP) est toujours un bon point de départ. Il est même utile de voir comment les choses ont évolué au fil du temps. Dans l'édition 2008 du guide de style BJCP, les bières aigres étaient classées dans une seule catégorie (le numéro 17 pour être précis) et qui contenait six sous-catégories de styles de bière aigres spécifiques.
(PLUS: Cours Beer 101 de CraftBeer.com)
 Actuellement, le guide de style BJCP reconnaît deux catégories complètes différentes pour un total de neuf styles différents et une autre bière est désormais répertoriée de manière plus appropriée dans la catégorie Bière historique pour un total général de 10 styles de bière différents qui sont tous reconnus comme étant acides.
Actuellement, le guide de style BJCP reconnaît deux catégories complètes différentes pour un total de neuf styles différents et une autre bière est désormais répertoriée de manière plus appropriée dans la catégorie Bière historique pour un total général de 10 styles de bière différents qui sont tous reconnus comme étant acides.
Il va sans dire également que les sombres alchimistes de l’alcool sont loin d’avoir fini d’étoffer cette liste de catégories de style. L’un des 10 styles étant simplement la Wild Specialty Beer, une catégorie aussi vague demande simplement à être divisée et clarifiée. Mais tout cela à temps.
Pour l'instant, nous pourrions nous contenter de produits comme
Comment savoir quoi choisir ou par où commencer ?
Ces bières funky et acidulées sont un goût acquis. Il n’y a pas deux façons de procéder. Mais si vous ne l’essayez jamais, la seule chose que vous pourrez garantir, c’est que vous ne pourrez jamais l’apprécier.
Le mieux est de faire vos devoirs et de rechercher un style de bière proche de votre style préféré. Il est juste de supposer que si vous n’aimez pas les bières rouges, un rouge flamand n’est peut-être pas le meilleur point de départ. Si vous aimez une bière blanche, essayez une gosse. Si vous aimez les bières allemandes, essayez une Berliner Weisse. Vous n'avez pas de favori ? Tu es parfait ! Allez-y et plongez pour voir ce qui se passe.
bières d'Halloween
(APPRENDRE: Guide des styles de bière de CraftBeer.com)
Parlant d'un moment de popularité à partir de notre expérience personnelle, les bières de blé légères et acidulées, la Berliner Weisse et la gose, comptent facilement parmi les bières aigres les plus populaires produites par les brasseries. Cela est logique, car ils se ressemblent à bien des égards et leur teneur élevée en acide lactique les rend acidulés et rafraîchissants.
Quel que soit ce que vous choisissez, la chose la plus importante à retenir lorsque vous dégustez une nouvelle bière est que le brassage est un travail d'amour. Si vous n’aimez pas une bière, c’est certainement votre prérogative, mais il est préférable de reconnaître que cela ne la rend pas nécessairement mauvaise – mais peut-être pas celle qu’il vous faut.
Que puis-je accompagner d’une bière aigre ?
Les bières aigres sont délicieuses et leur nature acidulée peut les rendre nettoyantes pour le palais. Cependant, leur nature acidulée les rend aussi parfois accablants. Par conséquent, tout ce que vous cherchez à accompagner de sours doit pouvoir se défendre dans l’assiette pour ne pas être submergé.
À ce stade, vous êtes sûr que je vais vous proposer un plat extrêmement élaboré qu’il serait difficile de trouver en dehors d’un restaurant 5 étoiles. Cependant, curieusement, un bon vieux barbecue fait un travail décent.

En résumé, les bières acidulées, les grillades fortes, les poissons, les crustacés (crabes et moules), les salades légères et les prunes se marient extrêmement bien.
(OUTILS D'APPARIEMENT : Guide des accords bières et mets)
Si les bières funky Brett vous plaisent davantage, vous constaterez que les saveurs terreuses se marient bien avec ces bières. Recherchez des plats classiques aux saveurs comme les pommes de terre et les champignons.
Ce ne serait pas une évaluation très juste du pouvoir de l’aigre si je ne proposais pas un accord personnel tiré de ma propre expérience. Un accord personnel préféré est une Berliner Weisse avec un plat de poulet au curry et de riz. Je pense que l'acidité aide à éliminer les épices et que les légères saveurs d'agrumes se marient bien avec le curry fort et piquant.
Même au-delà de la nourriture, vous pouvez associer ces bières avec beaucoup de choses différentes. La variété de l'aigre ne fait qu'augmenter sa polyvalence et elle peut être également appréciée à une table de dîner chic au milieu d'une plage de sable baignée de soleil ou sur un porche arrière grinçant au milieu de l'herbe fraîche coupée.
L'avenir de la bière aigre
Un mot : contrôle. Et c’est un concept assez puissant.
L’un des mots rarement prononcés par un nouveau brasseur est la reproductibilité. En effet, lorsque quelqu'un se lance dans l'aventure du brassage de ses propres recettes, la reproductibilité sera très difficile.
Nous n’exploitons que très délicatement le formidable pouvoir de la fermentation. Il peut être difficile de forcer ces petits soldats microbiens à faire encore et encore la même chose. Cela peut être particulièrement vrai pour les levures sauvages et les fermentations spontanées.
La science lève une partie du mystère pour permettre aux brasseurs de mieux comprendre les profils de saveurs qu’ils produisent. En bref, les sours ne vont nulle part mais augmentent.
Les bières acidulées sont peut-être notre porte d’entrée pour goûter aux temps anciens, mais elles peuvent aussi être notre fenêtre sur l’avenir. C’est une période passionnante pour un cours de bière passionnant. Demandez à votre barman ou brasseur et essayez-le.
Buvez dans le passé et portez un toast à l’avenir des brasseurs artisanaux indépendants américains.
Sauvegarder

Andrew Jockers
Andrew Jockers est un étudiant en médecine dentaire dans le monde réel, mais il travaille pour Voodoo Brewing Company en tant que barman dans leur salon de Homestead pour l'aider à maintenir sa santé mentale. Il travaille également comme représentant d'événements pour Voodoo dans la région de Pittsburgh, élève son fils nouveau-né avec sa belle épouse et aime écrire en freelance lorsqu'il a un moment pour respirer. Dans tous les temps libres dont il ne dispose pas, Andrew aime aussi la musique, le rugby, la randonnée et le rafting.
CraftBeer.com est entièrement dédié aux petites brasseries américaines indépendantes. Nous sommes publiés par la Brewers Association, un groupe commercial à but non lucratif dédié à la promotion et à la protection des petits brasseurs artisanaux indépendants d’Amérique. Les histoires et opinions partagées sur CraftBeer.com n’impliquent pas l’approbation ou les positions prises par l’Association des Brasseurs ou ses membres.














